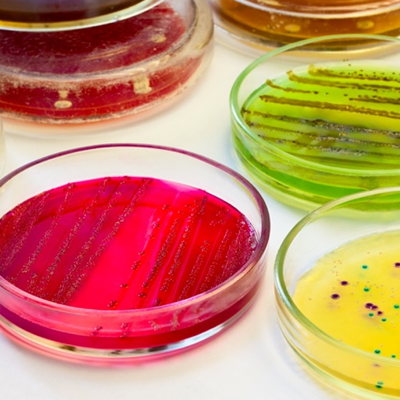
MIB-CM® Microbiology Reagents

Research Area

We provide the wonderful one-stop antifungal drug discovery platform against various potential targets and fungal species. From the target identification to the final IND-Enabling, our complete procedure has the capability to enable you to free up your time for core work and project.
Creative Biolabs provides the one-stop antibacterial drug discovery services against severe bacterial pathogens. From the target identification to the final IND-Enabling, we offer customized proposals to meet your project requirements in the quality, timeline, and budget.
Creative Biolabs is a world leading biotechnological company in research and development of agents in the field of antifungal and antibacterial drug discovery. Now we can provide a series of MIB-CM® reagents to assist microbiology research for our customs all over the world.
For Research Use Only.